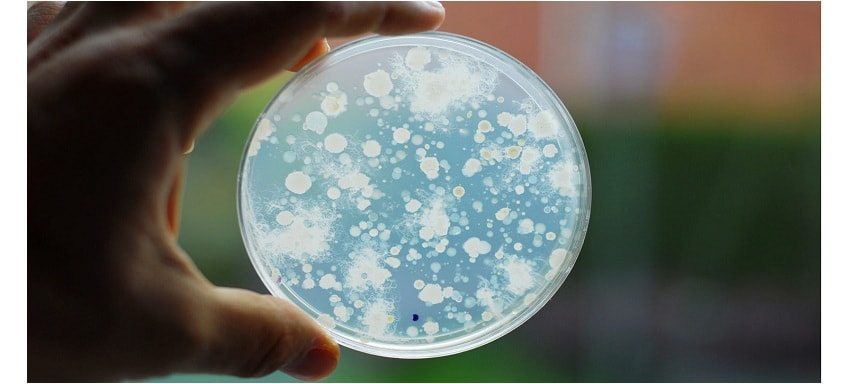

Antabio SAS, a biopharmaceutical company developing novel antibacterial treatments in areas of highest unmet needs, announced today the completion of a €7.3M series.
A financing with subscriptions from investment funds iXO Private Equity, IRDI SORIDEC Gestion, Galia Gestion and from the company’s historical investors including former President of OM Pharma Christophe Ricard.
The funding will be used to accelerate the development, up to completion of Phase 1 clinical trials, of Antabio’s novel inhibitor of bacterial metallo ß-lactamases (“MBLIs”) which will be combined with a carbapenem to fill an important gap in the treatment of drug-resistant infections. This financing complements the recent CARB-X grant of up to $8,9 million awarded to Antabio in July 2017 to support the company’s Elastase Inhibitor program (PEI) for the treatment of chronic Pseudomonas infections in Cystic Fibrosis patients.
“We are delighted to welcome iXO Private Equity, Irdi Soridec and Galia Gestion to Antabio, and we are honored by the continued solid support of our historical investors” said Marc Lemonnier, CEO of Antabio. “This new financing, coupled with the non-dilutive funding recently received from CARB-X, will advance Antabio’s innovative programs into clinical studies, thereby accelerating the development of our novel approaches to treat infections caused by WHO’s priority pathogens”.
“We initiate this collaboration with the Antabio team with a lot of enthusiasm” said Jean-Michel Petit, Investment Director at IRDI Soridec Gestion. “Beyond the compelling medical need, we have been impressed with the professionalism of the team and the quality of the programs developed at Antabio, which have already earned the support of global organizations such as the Wellcome Trust and CARB-X”.
About iXO Private Equity
iXO PE is the most important independent regional private equity General Partner in France dedicated to small and small-mid cap through buyout and growth transactions. The company manages over €610m assets within various French General Private Equity Investment Funds (known in France as FPCI), Local Private Equity Investment Fund (known in France as FIP), and Private Equity Investment Funds for Innovation (FCPI) covering a broad range of investments from €2m to €15m per project. Based in Toulouse, Marseille and Lyon, iXO Private Equity is able to meet all financing needs of small and midcap companies in order to create, develop and hand down from across his 3 investments types : Venture Capital, Growth Capital, LBO / OBO / MBO. Each of the four Partners oversees a given geographical area in South-West and South-East France and Rhône-Alpes.
About Irdi Soridec Gestion
Created 35 years ago, IRDI SORIDEC Gestion is one of the leading French regional capital investment firm with over € 200 million under management. Its ever-green structure confers to IRDI its longevity over time. Its shareholders are leading players including Bpifrance, the Occitanie and Nouvelle-Aquitaine Regions, the Caisse d’Epargne Midi-Pyrenees, the Banque Populaire Group, LCL – Crédit Agricole, EDF, Total Development Regional and Ionis. IRDI SORIDEC Gestion invests and supports innovative companies, located in the South West of France. It manages multi-sectoral funds specialized in seed, venture capital, buyout or growth equity investing up to € 10 million per company.
About Galia Gestion
Galia Gestion is investing in companies based in the Southwest of France. Galia Gestion invests from 300 K€ up to 4 M€ in Venture, Growth and LBO operation. Since 2002 Galia Gestion has raised more than 150 M€. Contact : Pierre Arnaud – pierre.arnaud@galia-gestion.com
About ANTABIO
Antabio is a private biopharmaceutical company developing novel antibacterial resistance-breakers to treat drug-resistant infections in areas of highest unmet medical need. Two of Antabio’s programs have received Wellcome Trust Seeding Drug Discovery Awards to date: (i) a novel, safe and efficacious inhibitor of bacterial metallo ß-lactamases to be combined with a carbapenem for the treatment of drug-resistant nosocomial infections and (ii) a first-in-class inhibitor of Pseudomonas virulence to be co-administered with standard-of-care antibiotics for the long-term management of chronic respiratory infections. This second program has recently received up to $8.9 million funding from the Combating Antibiotic Resistant Bacteria Biopharmaceutical Accelerator (CARB-X). The company’s lead product is expected to enter the clinic in 2019 with a fast track to anticipated marketing approval by 2021. Antabio has built a best in class, international team of experts in the field to progress its pipeline. The Company is in the process of acquiring additional assets focused on Gram-negative antibiotic resistant therapies.
Contact
Carine Bonnet-Danaire
+33 5 31 47 18 57
press@antabio.com
www.antabio.com
@antabio